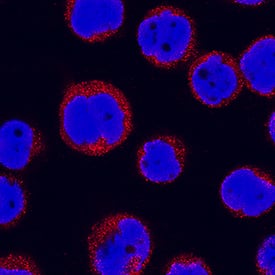
IL-31 RA antibody in THP-1 Human Cell Line by Immunocytochemistry (ICC).

Human IL-31RA Antibody
R&D Systems, part of Bio-Techne | Catalog # AF2769


Key Product Details
Species Reactivity
Validated:
Cited:
Applications
Validated:
Cited:
Label
Antibody Source
Product Specifications
Immunogen
Ala20-Ser516
Accession # Q8NI17
Specificity
Clonality
Host
Isotype
Scientific Data Images for Human IL-31RA Antibody
Detection of IL-31RA in U937 Human Cell Line by Flow Cytometry.
U937 human histiocytic lymphoma cell line was stained with Goat Anti-Human IL-31 RA Antigen Affinity-purified Polyclonal Antibody (Catalog # AF2769, filled histogram) or isotype control antibody (Catalog # AB-108-C, open histo-gram), followed by Phycoerythrin-conjugated Anti-Goat IgG Secondary Antibody (Catalog # F0107).IL‑31 RA in K562 Human Cell Line.
IL-31 RA was detected in immersion fixed K562 human chronic myelogenous leukemia cell line using Goat Anti-Human IL-31 RA Antigen Affinity-purified Polyclonal Antibody (Catalog # AF2769) at 5 µg/mL for 3 hours at room temperature. Cells were stained using the NorthernLights™ 557-conjugated Anti-Goat IgG Secondary Antibody (red; Catalog # NL001) and counterstained with DAPI (blue). Specific staining was localized to cell surfaces and cytoplasm. View our protocol for Fluorescent ICC Staining of Non-adherent Cells.IL‑31 RA in THP‑1 Human Cell Line.
IL-31 RA was detected in immersion fixed THP-1 human acute monocytic leukemia cell line using Goat Anti-Human IL-31 RA Antigen Affinity-purified Polyclonal Antibody (Catalog # AF2769) at 15 µg/mL for 3 hours at room temperature. Cells were stained using the NorthernLights™ 557-conjugated Anti-Goat IgG Secondary Antibody (red; Catalog # NL001) and counterstained with DAPI (blue). Specific staining was localized to cytoplasm. View our protocol for Fluorescent ICC Staining of Non-adherent Cells.Applications for Human IL-31RA Antibody
CyTOF-ready
Flow Cytometry
Sample: U937 human histiocytic lymphoma cell line
Immunocytochemistry
Sample: Immersion fixed U937 human histiocytic lymphoma cell line, immersion fixed K562 human chronic myelogenous leukemia cell line, and immersion fixed THP-1 human acute monocytic leukemia cell line
Western Blot
Sample: Recombinant Human IL-31 RA (Catalog # 2769-IL)
Formulation, Preparation, and Storage
Purification
Reconstitution
Formulation
Shipping
Stability & Storage
- 12 months from date of receipt, -20 to -70 °C as supplied.
- 1 month, 2 to 8 °C under sterile conditions after reconstitution.
- 6 months, -20 to -70 °C under sterile conditions after reconstitution.
Background: IL-31RA
The interleukin-31 receptor A subunit (IL-31 RA), also known as gp130-Like Monocyte Receptor (GLM-R or GPL), is a ~100 kDa type I transmembrane glycoprotein that is classified as being a type I cytokine receptor (1, 2). A heterodimeric complex of IL-31 RA and the oncostatin M receptor (OSM-R) functions as the signaling receptor for IL-31 (3). Both subunits are inducibly expressed throughout the myelomonocytic lineage and are upregulated by interferon-gamma and bacterial lipopolysaccharides (1‑3). IL-31 RA is also expressed on keratinocytes, dorsal root ganglia neurons, and variably on lung epithelial cells (3‑6). The 732 amino acid (aa) IL-31 RA contains a 19 aa signal sequence, a 500 aa extracellular domain (ECD), a 21 aa transmembrane domain and a 192 aa cytoplasmic domain. The ECD shares 60%, 58%, 73% and 70% aa identity with mouse, rat, canine and bovine IL-31 RA ECD, respectively. Human IL-31 receptors do not respond to mouse IL-31 (7). The ECD contains five fibronectin type III domains; the first two contain four conserved cysteine residues and a WSXWS motif common to type I cytokine receptors (2). Twelve alternately spliced human IL-31 RA isoforms are known and range in size from 356‑745 amino acids. A long (745 aa) and a short (560 aa) transmembrane form are the predominant forms, and many cell lines express both forms (8). The long form, like the 732 aa form, signals by recruiting STAT3, 5 or 1, while the short form does not recruit STATs and inhibits IL-31 signaling. The ratio of these forms and their co-expression with OSM-R determines a cell’s response to IL‑31 (8). In both humans and transgenic mice, IL-31 from skin-homing Th2 cells may contribute to the pruritis (itching) associated with nonatopic dermatitis, especially in infected skin (3, 9, 10).
References
- Ghilardi, N. et al. (2002) J. Biol. Chem. 277:16831.
- Diveu, C. et al. (2003) J. Biol. Chem. 278:49850.
- Dillon, S. R. et al. (2004) Nat. Immunol. 5:752.
- Chattopadhyay, S. et al. (2007) J. Biol. Chem. 282:3014.
- Perrigoue, J. G. et al. (2007) J. Exp. Med. 204:481.
- Bando, T. et al. (2006) Neuroscience 142:1263.
- Broxmeyer, H. E. et al. (2007) Exp. Hematol. 35:78.
- Diveu, C. et al. (2004) Eur. Cytokine. Netw. 15:291.
- Bilsborough, J. et al. (2006) J. Allergy Clin. Immunol. 117:418.
- Sonkoly, E. et al. (2006) J. Allergy Clin. Immunol. 117:411.
Long Name
Alternate Names
Gene Symbol
UniProt
Additional IL-31RA Products
Product Documents for Human IL-31RA Antibody
Product Specific Notices for Human IL-31RA Antibody
For research use only